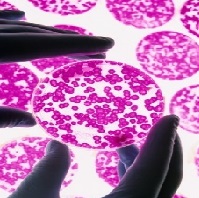

Previous Events
SBM Insights: A Webinar Series
This thematic webinar series is an opportunity for both offer holders and prospective students to connect with our academic and professional services staff via creative panel discussions. Click the link below to see the various webinars we'll have going through May and reoccuring in June.
Discover our themed webinars here
Tuesday, May 19, 2026, 3:30 PM
This 1.5-hour walking seminar explores Hackney as a living archive shaped by migration, labour, and collective struggle.
 Data as Resistance: Feminist and Trans Interventions in Data and AI
Data as Resistance: Feminist and Trans Interventions in Data and AITuesday, April 28, 2026, 4:00 PM
Join us for an online panel exploring how data and AI are used to challenge gender-based violence. The panel features three presentations: Data Against Feminicide, showcasing activist-led projects documenting gender-related killings; participatory media workshops, highlighting feminist approaches to news and knowledge hierarchies; and transformative data science by trans activists, focusing on data practices that centre trans communities.
 Borderlines Workshop: Discourse Analysis (Theory and Method)
Borderlines Workshop: Discourse Analysis (Theory and Method)Friday, April 17, 2026, 11:00 AM
Borderlines is hosting an online workshop on Discourse Analysis: Theory and Method with Dr Suyash Barve. This workshop particularly suitable for PhD students and early career researchers.
.jpg) Fast Track to Masters - For Queen Mary Year 2 & Year 3 Students
Fast Track to Masters - For Queen Mary Year 2 & Year 3 StudentsWednesday, April 15, 2026, 12:00 PM
Thinking about what comes after your undergraduate degree? Discover how you can progress directly to a Masters with the School of Business and Management at Queen Mary and gain the skills to stand out in a competitive global job market.
Open to all Year 2 & Year 3 Queen Mary University of London undergraduate students.
Friday, March 27, 2026, 3:00 PM
Borderlines is thrilled to invite you to this reflexive session, a continuation of the conversation begun during our February panel on Mothering Across Borders: Ayahs, Migration, and Racialised Care. We’ll have tea, coffee, and some sweet snacks to make it a proper afternoon pause.
.png) Masters Online Information Sessions 2026
Masters Online Information Sessions 2026 Wednesday, March 25, 2026, 11:00 AM
Thinking about studying a Masters at the School of Business and Management? Then join us for our online Masters Information Sessions.
 Seminar 3 of Global Dialogue Series on AI, Voice, and Decolonial Knowledge
Seminar 3 of Global Dialogue Series on AI, Voice, and Decolonial KnowledgeTuesday, March 24, 2026, 5:00 PM
How is AI influencing which stories are preserved and which are erased? This seminar will consider the impact of AI on archives, oral histories, and storytelling traditions across digital and non-digital worlds.
 SBM Industry Spotlight Series: Careers in Consulting, Advisory and Strategy
SBM Industry Spotlight Series: Careers in Consulting, Advisory and StrategyWednesday, March 18, 2026, 4:00 PM
Interested in a career where problem-solving, strategic thinking, and real-world impact come together? Join us for the next SBM Industry Spotlight session exploring careers in consulting, advisory, and strategy.
 Tokenisation and Environmental Disclosure: Implications for Accounting
Tokenisation and Environmental Disclosure: Implications for AccountingFriday, March 13, 2026, 10:00 AM
Join us in person for an insightful session on how tokenisation is changing the game in environmental disclosure and what this means for finance and accounting pros. We'll explore practical impacts, real-world examples, and future trends. Don't miss out on networking with experts and getting ahead in your field!
Speaker: Dr Alessandro Merendino and Dr Niki Panourgias
 Rise Up: Women in Business and Finance
Rise Up: Women in Business and FinanceWednesday, March 11, 2026, 10:00 AM
Join us at Rise Up: Women in Business and Finance, a free, on-campus event exclusively for women in Years 10 –12 who want to explore future study and career opportunities in business and finance.
 QS Masters Fair in Ankara Turkey
QS Masters Fair in Ankara TurkeySunday, March 1, 2026, 1:00 PM
Meet us in person at the QS Masters fair in Ankara.
.png) QS Masters Fair in Istanbul
QS Masters Fair in IstanbulSaturday, February 28, 2026, 1:00 PM
Speak to us in person in Istanbul at the QS Masters Fair.
 VR Experience “Kamukuwaká: A Call of the Forest”
VR Experience “Kamukuwaká: A Call of the Forest” Wednesday, February 25, 2026, 1:00 PM
 Panel Discussion: Beyond COP30: Closing the gap between talk and action
Panel Discussion: Beyond COP30: Closing the gap between talk and actionMonday, February 23, 2026, 6:15 PM
As part of Climate Action Week 2026, Queen Mary University of London is hosting events that explore how climate action moves from global negotiations to cultural, research-led, and community-driven change. "Beyond COP30: Closing the gap between talk and action" brings together Queen Mary researchers and partners to reflect on COP30 outcomes and the future of climate justice.
 Masters Open Event
Masters Open Event Wednesday, February 18, 2026, 4:30 PM
Join our next Masters open event on campus!
 Global Dialogue Seminar Series, Seminar 2: Who speaks? AI and the politics of research, education, and creativity
Global Dialogue Seminar Series, Seminar 2: Who speaks? AI and the politics of research, education, and creativityTuesday, February 10, 2026, 12:30 PM
We are thrilled to invite you to the second seminar of the Global Dialogue Series on AI, Voice, and Decolonial Knowledge!
Friday, February 6, 2026, 10:00 AM
The School of Business and Management is pleased to announce an upcoming visit from Professor Anna Maria Paganoni, Lead of Data Strategy at Politecnico di Milano, who will join us as a CGR-SBM invited external speaker. Professor Paganoni will deliver an academic seminar entitled “The Data Strategy at Politecnico di Milano: Addressing the Dropout Problem.”
.png) Welcome Week: Postgraduate Social Event
Welcome Week: Postgraduate Social EventWednesday, February 4, 2026, 5:00 PM
Join us for a relaxed, in-person social evening designed to help you meet fellow postgraduate students from the School of Business and Management and settle into life at Queen Mary University of London.
 Borderlines Workshop: What Does Decolonial Feminist Research on Migration Look Like?
Borderlines Workshop: What Does Decolonial Feminist Research on Migration Look Like? Thursday, January 29, 2026, 5:00 PM
What happens when we centre migrant women’s voices not as subjects of research, but as producers of knowledge?
This interactive workshop introduces decolonial feminist approaches that challenge Eurocentric and patriarchal ways of studying migration.
 SBM Industry Spotlight Series: Careers in Finance, Accounting and Fintech
SBM Industry Spotlight Series: Careers in Finance, Accounting and FintechWednesday, January 28, 2026, 4:00 PM
Curious about where a career in finance, accounting, or fintech can take you? Join us for the next SBM Industry Spotlight event!
Thursday, January 22, 2026, 1:30 PM
Welcome January 2026 intake students! You are warmly invited to attend the City Finance Walking Tour.
Wednesday, January 21, 2026, 4:00 PM
Starting your postgraduate journey can feel overwhelming, but you don’t have to navigate it alone. The Meet Your Advisor event is designed especially for January-intake postgraduate students, offering a relaxed and welcoming introduction to the support available to you.
Tuesday, January 20, 2026, 1:30 PM
As part of our Welcome Week for January starters, we’re inviting new students to take part in the Silicon Roundabout Tech Tour - an in-person experience that brings you face to face with London’s thriving tech innovation scene.
 Whose Knowledge? Anti-racist and Decolonial Perspectives on AI Governance and Knowledge Systems
Global Dialogues Series
Whose Knowledge? Anti-racist and Decolonial Perspectives on AI Governance and Knowledge Systems
Global Dialogues Series Tuesday, December 2, 2025, 5:00 PM
Join us for the first session of our virtual seminar series, Global Dialogues on AI, Voice, and Decolonial Knowledge, co-organised with the Institute for Creative Futures at Loughborough University London.
The series explores how AI is reshaping authorship, creativity, and human understanding through a critical and decolonial lens, bringing together speakers from across the Global South and Global North.
 SBM Industry Spotlight Series: Careers in HR and People Strategy
SBM Industry Spotlight Series: Careers in HR and People StrategyWednesday, November 19, 2025, 4:00 PM
Curious about where a career in Human Resources can take you? Join us for the next SBM Industry Spotlight event to hear from professionals working in HR, talent management, and people strategy across industries, including health, higher education and more.
For the School of Business and Management Students only
.png) The Employers Address 2025
The Employers Address 2025Wednesday, November 12, 2025, 5:30 PM
The Employer’s Address returns to Queen Mary this November for an evening of insight and collaboration at the intersection of business, education, and emerging talent. We warmly invite students, graduates, academics, and professionals to join us for this inspiring evening of insight, collaboration, and networking.
-JPG.jpg) SBM Industry Spotlight Series: Careers in Marketing, Comms and Digital Media
SBM Industry Spotlight Series: Careers in Marketing, Comms and Digital MediaWednesday, November 12, 2025, 4:00 PM
Curious about where a career in marketing can take you? Join us for the next SBM Industry Spotlight event to hear from alumni working in marketing, communications, and digital media across a variety of sectors.
 Exclusive LinkedIn Personal Branding Workshop for School of Business and Management Students
Exclusive LinkedIn Personal Branding Workshop for School of Business and Management Students Wednesday, November 12, 2025, 2:00 PM
Get ready to elevate your professional presence! The School of Business and Management invites its undergraduate and postgraduate students to an Exclusive LinkedIn Personal Branding Workshop designed to help you stand out in today’s competitive job market.
Delivered by LinkedIn experts, this interactive session will show you how to create a compelling profile, grow your professional network, and use LinkedIn’s tools to boost your career readiness.
Don’t miss this opportunity to gain insider tips and prepare for future success!
 Demystifying Post-Colonial Consumption and Markets
Demystifying Post-Colonial Consumption and MarketsWednesday, November 12, 2025, 1:30 PM
Join us for a workshop designed for doctoral researchers interested in marketing, consumption, and critical theory. Led by Professor Rohit Varman (University of Birmingham), the session explores how post-colonial perspectives can uncover the power structures shaping global markets. Moving beyond cultural or ethnic readings, it examines how capitalism, inequality, and historical legacies influence consumption and development. Hosted with the MINDS and Borderlines research groups, the event encourages critical reflection on how knowledge, power, and markets intersect.
 AI, Analytics & You: Smarter Business in a Data-Driven Future - Futures Made Different. A Webinar Series.
AI, Analytics & You: Smarter Business in a Data-Driven Future - Futures Made Different. A Webinar Series. Thursday, November 6, 2025, 11:00 AM
Data is the new currency of business – but how do you turn it into action?
From AI-powered insights to predictive modelling and digital campaign optimisation, this session explores how data is reshaping strategy, marketing, and management. Hear from faculty who bridge advanced analytics with business practice and discover how you can build future-proof skills.
Speaker: Dr Georg Graevenitz, Dr Swagato Chatterjee and Dr Farrah Arif
.png) Future Leaders: Management Skills for a Changing World - Futures Made Different. A Webinar Series.
Future Leaders: Management Skills for a Changing World - Futures Made Different. A Webinar Series. Wednesday, November 5, 2025, 11:00 AM
Organisations need leaders who can manage uncertainty, inspire teams, and adapt to rapid change.
This session highlights the management and leadership skills employers seek - from financial decision-making to strategic agility. Learn how Queen Mary’s master’s programmes prepare graduates to step confidently into managerial roles worldwide.
Speaker: Dr Nadia Zahoor and Dr Nikiforos Panourgias
 From London to the World: Building Careers in Global Business - Futures Made Different. A Webinar Series.
From London to the World: Building Careers in Global Business - Futures Made Different. A Webinar Series. Tuesday, November 4, 2025, 11:00 AM
How do businesses thrive across borders in an age of shifting supply chains, new trade blocs, and rising sustainability demands?
This session explores what it takes to manage global organisations, build responsible strategies, and lead people across cultures. Students will learn how Queen Mary’s programmes equip them to drive impact in international careers.
Speaker: Dr Jessica Sklair, Dr Eun-Seok Kim and Dr Chris McLachlan
 Finance in Flux: Accounting, Risk & the Global Economy - Futures Made Different. A Webinar Series.
Finance in Flux: Accounting, Risk & the Global Economy - Futures Made Different. A Webinar Series. Friday, October 31, 2025, 11:00 AM
In a world of shifting markets and regulatory change, finance professionals need new tools and perspectives.
This session explores how global finance is adapting – from risk management to sustainability in accounting – and why advanced skills are more vital than ever. Learn how Queen Mary’s finance and accounting programmes prepare you for leadership in a volatile world.
Speaker: Dr Nicholas Tsitsianis, Dr Nikiforos Panourgias and Dr Stravroula Yfanti
 Brands in the Feed: Marketing that Moves People - Futures Made Different. A Webinar Series.
Brands in the Feed: Marketing that Moves People - Futures Made Different. A Webinar Series. Thursday, October 30, 2025, 1:30 PM
From TikTok virality to global brand campaigns, marketing is more dynamic than ever.
This session dives into how businesses capture attention, build trust, and drive sales in the digital age. Students will see how creativity meets analytics, and how studying at Queen Mary offers the perfect platform to launch an international marketing career.
Speaker: Dr Mina Tajvidi, Dr Sevil Yesiloglu and Dr Zafeirenia Brokalaki
 Startup Stories: Turning Ideas into Impact - Futures Made Different. A Webinar Series.
Startup Stories: Turning Ideas into Impact - Futures Made Different. A Webinar Series. Wednesday, October 29, 2025, 11:00 AM
What does it take to launch a successful venture in today’s economy?
This session explores entrepreneurship in practice – from scaling start-ups and social enterprises to blockchain and creative innovation. Hear how Queen Mary’s entrepreneurial ecosystem supports students to think differently, test ideas, and lead ventures that matter.
Speaker: Dr Gloria Appiah, Dr Sayed Elhoushy and Dr Zeynep Gurguc
 2026: Challenges and Opportunities in Creative Industries - Futures Made Different. A Webinar Series.
2026: Challenges and Opportunities in Creative Industries - Futures Made Different. A Webinar Series.Tuesday, October 28, 2025, 12:00 PM
This session explores the current challenges and opportunities within the sector of business, creativity, and heritage management. See how Queen Mary’s unique programmes prepare them for leadership roles in the cultural and creative economy.
Speaker: Dr Ed Legon, Dr Amitabh Rai and Dr Gavin Grindon
.png) From Campus to Big 4
From Campus to Big 4Thursday, October 2, 2025, 6:15 PM
Get insights and network with Deloitte, EY, KPMG and PwC.
.png) Postgraduate Social - School of Business and Management
Postgraduate Social - School of Business and ManagementWednesday, October 1, 2025, 5:00 PM
Celebrate the start of your Queen Mary journey with our postgraduate social for students at the School of Business and Managment.
.png) SBM Industry Spotlight Series: QMUL Alumni – From Campus to Career
SBM Industry Spotlight Series: QMUL Alumni – From Campus to CareerWednesday, October 1, 2025, 4:00 PM
What if you could fast-forward and visualise your future career?
This special panel event will showcase the diverse career journeys of QMUL graduates. You’ll get real stories, honest advice, and insider tips from our graduates who’ve turned their degrees into exciting careers across areas like Finance, Marketing, HR, Public sector and more.
 Undergraduate Meet Your Advisor BBQ Social - School of Business and Management
Undergraduate Meet Your Advisor BBQ Social - School of Business and ManagementFriday, September 19, 2025, 3:00 PM
A welcoming BBQ to meet your advisor and connect with other undergraduates in the School of Business and Management.
 Postgraduate Welcome Week: City Finance and Retail Design Tours - School of Business and Management
Postgraduate Welcome Week: City Finance and Retail Design Tours - School of Business and ManagementThursday, September 18, 2025, 3:00 PM
Postgraduate students are invited to explore London’s financial and retail hubs with a specialist guided tour.
Sign up for the London City Finance Tour
Sign up for the West End Retail Design Tour
 BSc Accountancy Welcome Week BBQ - School of Business and Management
BSc Accountancy Welcome Week BBQ - School of Business and ManagementWednesday, September 17, 2025, 3:00 PM
A dedicated BBQ by the canal for Accountancy and Flying Start students to meet staff and peers.
.png) BSc Accountancy/Flying Start Welcome Week Breakfast - School of Business and Management
BSc Accountancy/Flying Start Welcome Week Breakfast - School of Business and ManagementWednesday, September 17, 2025, 9:00 AM
A dedicated breakfast for BSc Accountancy and Flying Start students to meet staff and peers.
 Undergraduate Welcome Week Breakfast 2025 - School of Business and Management
Undergraduate Welcome Week Breakfast 2025 - School of Business and Management Wednesday, September 17, 2025, 9:00 AM
Kick off Welcome Week with breakfast alongside your fellow undergraduate students at the School of Business and Management and start building friendships in a relaxed setting.
 Postgraduate Meet Your Advisor BBQ Social - School of Business and Management
Postgraduate Meet Your Advisor BBQ Social - School of Business and ManagementTuesday, September 16, 2025, 4:00 PM
 Undergraduate Welcome Week: City Finance and Retail Design Tours - School of Business and Management
Undergraduate Welcome Week: City Finance and Retail Design Tours - School of Business and ManagementTuesday, September 16, 2025, 3:00 PM
Undergraduate students at the School of Business and Management are invited to explore London’s financial and retail hubs with a specialist guided tour.
 Postgraduate Welcome Week Breakfast 2025 - School of Business and Management
Postgraduate Welcome Week Breakfast 2025 - School of Business and ManagementTuesday, September 16, 2025, 9:00 AM
 Step Ahead Plus Programme BBQ Social (School of Business and Management)
Step Ahead Plus Programme BBQ Social (School of Business and Management)Tuesday, September 9, 2025, 4:00 PM
Connect with fellow Step Ahead Plus programme participants in a relaxed BBQ by the canal. A perfect opportunity to make friends and ease into university life before the semester begins.
Learn more about Step Ahead Plus.
 QMUL to host UK Social Marketing Conference 14th September 2017
QMUL to host UK Social Marketing Conference 14th September 201714 September 2017
As key partners of the first UK Social Marketing Conference, Queen Mary University, the European Social Marketing Association, NSMC, Strategic Social Marketing and Fuse Events invite you to join us at the first cross sector event for change makers across the UK in nearly ten years.
 Inaugural Lecture of Professor Frances Bowen
Inaugural Lecture of Professor Frances Bowen 13 June 2017
Join Professor Frances Bowen, Head of the School of Business and Management for her inaugural lecture: 'Making a Splash! What companies say and do about water'. At the event on Tuesday 13 June 2017, 6:30pm Professor Frances Bowen will outline the business challenges and opportunities arising from water issues. She will present the results of recent research on corporate water strategies of large UK-based businesses, focusing on what companies say and do about water. Book your free place now for the lecture of the year.
12 June 2017
In this two-day meeting, we will consider how the fields of behavioural finance, economic psychology, financial socio-analysis and other related areas can enhance our understanding of financial behaviours.
 Upcoming Alumni Events in China and Thailand, May 2017
Upcoming Alumni Events in China and Thailand, May 201720 May 2017
Dr Stefan Krummaker, Senior Lecturer in Leadership & Director of Taught Programmes for the School of Business and Management would like to invite our former students to join him at one of the upcoming alumni events in Beijing, Shanghai or Guangzhou in May 2017. Stefan looks forward to catching up with our alumni over drinks and canapés to find out what they have been up to since graduation and moreover this will be a great opportunity for our graduates to network with former students who studied at Queen Mary, work in their industry or one that they are interested in. To confirm your attendance to any of these events please register at the following links below. The password for all events are SBM2017 (all caps). If you experience any issues with registering email sbm-alumni@qmul.ac.uk or contact our Alumni Relations and Events Officer, Alicia George on alicia.george@qmul.ac.uk. We do hope that you can attend for Stefan looks forward to welcoming you to these events on behalf of the School of Business and Management.
 The Centre for Globalisation Research First Brown Bag Seminar on 17th May 2017
The Centre for Globalisation Research First Brown Bag Seminar on 17th May 201717 May 2017
The Centre for Globalisation Research at the School of Business and Management, Queen Mary University of London, will be hosting its first brown bag seminar on Wednesday 17th May 2017. Please join Professor Pedro Martins, Director for the Centre for Globalisation Research and his colleagues who will be presenting a series of academic papers at this auspicious event.
 Public Lecture by Henry Mintzberg: Journey in pursuit of a re-balanced society
Public Lecture by Henry Mintzberg: Journey in pursuit of a re-balanced society 10 May 2017
Henry Mintzberg's research focuses on managerial work, strategy formation, and forms of organizing, Henry has published a series of works.
10 May 2017
Revaluing the Mundane is an international colloquium for academics interested in rethinking economic and social problems and for practitioners involved in practical initiatives, including stakeholders from government and civil society organisations.
28 April 2017
The “Back to Basics” account focuses on values in addition to efficiency, including the values of autonomy and diversity. The third “basic” of the account refers to what has been termed, “the basic structure” – roughly, the main social and political institutions of society. In doing so, the “Back to Basics” emphasizes that there are limits to what business enterprises are permitted or required to do in order to respect the authority and legitimacy of legal and political institutions.
24 April 2017
The Marketing and Retail Special Interest Group of the British Academy of Management and the Marketing and Communications Group (MARCOMMS) of the School of Business and Management at Queen Mary University of London, are organising a one-day research workshop dedicated to the role of negative appeals and negative campaigning in marketing. The objective of the event is to present new research findings on this topic and discuss what roles these campaigns could have in marketing.
 Business Ecosystems Research Group (BERG) in collaboration with the Marketing Interactions and Consumer Behaviour Research Group (MICB)
Business Ecosystems Research Group (BERG) in collaboration with the Marketing Interactions and Consumer Behaviour Research Group (MICB)21 April 2017
The research groups of BERG and MICB are organising a seminar on submitting to and getting accepted by highly ranked journals in business and management.
 2017 CRED Annual Lecture
2017 CRED Annual Lecture29 March 2017
This presentation offers insights into the toxic effects of racism at work and presents new research that deepens our understanding of its insidious and pervasive effects. Like “second hand smoke” our research reveals that the harmful repercussions of racism extend well beyond the target to impact third-party bystanders in the workplace.
 The contested terrain of social media in employment
The contested terrain of social media in employment29 March 2017
A small body of emerging research suggests that employers are increasingly profiling employees and institutionalising social boundaries by codifying, monitoring and enforcing professional online conduct.
 QMUL Inaugural Lecture
QMUL Inaugural Lecture28 March 2017
As part of the QMUL Inaugural Lecture Series, Professor Sushanta Mallick examines how far the developing countries have come in their process of growth following the rapid pace of policy reforms in the 1990s; which he calls the “great liberalisation” of the 1990s.
 Meet the Editors Workshop
Meet the Editors Workshop22 March 2017
The School of Business and Management is organising a seminar on submitting to and getting accepted by highly ranked journals in business and management.
 Exploring Affective Practices in the Changing Context of Dirty Work
Exploring Affective Practices in the Changing Context of Dirty Work15 March 2017
The aim of this study is to explore dirty workers’ affective responses to chronic insecurities produced by the practices and logic of neoliberalism, and to demonstrate the centrality of affect in shaping the relationship with the past and the future.
 Toxic Roads, Unearthing Hazardous Toxic Waste Dumping
Toxic Roads, Unearthing Hazardous Toxic Waste Dumping1 March 2017
This talk will present its findings which investigate how new roads are used as burial sites for hazardous waste and the health implications this has on individuals who live nearby; with a particular focus on Ethiopia.
 Specialist CEOs and IPO survival
Specialist CEOs and IPO survival15 February 2017
This seminar will present findings that investigate the influence of a CEO’s specialist managerial experience on the probability of failure and survivability of IPO firms.
 Making countries more business-friendly: the role of international organisations
Making countries more business-friendly: the role of international organisations10 February 2017
Ken Davies is the former head of global relations at the OECD, and also worked as a Senior Economist at the Vale Columbia Center on Sustainable International Investment at Columbia University
Why is it difficult to get knowledge into practice?
Why is it difficult to get knowledge into practice?8 February 2017
This seminar will discuss and address general challenges to achieving change in complex organisational settings.
 School of Business and Management Alumni Breakfast Catch Up
School of Business and Management Alumni Breakfast Catch Up31 January 2017
The School of Business and Management would like to invite all SBM alumni to our Breakfast Catch Up. This will be a great opportunity to build networks with alumni who work in business and management industries over breakfast.
 Pension Accounting and Firm Value: A Dynamic Analysis
Pension Accounting and Firm Value: A Dynamic Analysis25 January 2017
"Pension Accounting and Firm Value: A Dynamic Analysis”
 Spillovers, inventions and the scale effects: A scrutiny of emerging world
Spillovers, inventions and the scale effects: A scrutiny of emerging world11 January 2017
R and D activities of emerging countries (EMEs) have increased considerably. We scrutinize inventions, spillovers and the “scale effects” in a large panel of EMEs.
 Friedman’s Presidential Address to the American Economic Association (1968) is not about expectations and the Phillips curve
Friedman’s Presidential Address to the American Economic Association (1968) is not about expectations and the Phillips curve14 December 2016
The research by Dr James Forder reconsiders the intentions of Friedman’s (1968) Presidential Address, his goals, and the relevance of the Phillips curve.
 The effect of female directors on firm performance
The effect of female directors on firm performance7 December 2016
The study, presented by Professor Colin Green, presents evidence in support of female representation on corporate boards, with a focus on firm performance and economic rationale.
 Coping with stigmatised identities: The experience of Romanian migrants in the UK
Coping with stigmatised identities: The experience of Romanian migrants in the UK23 November 2016
The paper presented by Dr Laura Morosanu looks at how Romanian migrants in the UK cope with stigmatised identities.
 How do we know what we know? Limits to consensus in an age of individualism
How do we know what we know? Limits to consensus in an age of individualism21 November 2016
Amy Boone is a writer and a Director of Effective Intervention, a charity that designs and implements aid projects in education and neonatal health, with an eye to measuring their actual impact in the developing world.
 Does empathy improve marketing performance? Evidence from a high autonomy sales environment in an emerging market
Does empathy improve marketing performance? Evidence from a high autonomy sales environment in an emerging market16 November 2016
Dr Sourindra Banerjee, Assistant Professor of Marketing, Warwick Business School, tackles the question: Why do some salespeople in high autonomy environments perform better than others?
 Politically connected businesses in emerging markets
Politically connected businesses in emerging markets14 November 2016
Simon Commander is Professor at IE Business School and Managing Partner of Altura Partners. He is extensively involved in advisory work of a policy and strategic nature principally with emerging market governments.
 Financial fragility: New measures and some results
Financial fragility: New measures and some results2 November 2016
Professor Panicos O'Demetriades presents research which shows the links between financial fragility and crises, and the effect these have on growth.
 China’s political economy
China’s political economy1 November 2016
Trey McArver is Director of China Research at Trusted Sources, an emerging markets macroeconomic research firm.
 From Borlaug's Paradox to the 'Eroom' Effect: Emerging challenges of sustainable development innovation
From Borlaug's Paradox to the 'Eroom' Effect: Emerging challenges of sustainable development innovation26 October 2016
Drawing on Brazilian and Canadian cases, Professor Jeremy Hall discusses two of the challenges for sustainable development innovation: 'Borlaug's Paradox' and the 'Eroom' Effect,
 Building Bridges. How investors cope with lower growth, lower return in market environment.
Building Bridges. How investors cope with lower growth, lower return in market environment.25 October 2016
Bill Street is a Senior Managing Director of SSGA and Head of Investments for EMEA and currently serves as a member of the European executive management committee as well as the SSGA Investment Committee.
 Crimes against women and economic conditions: Evidence from India
Crimes against women and economic conditions: Evidence from India19 October 2016
The study by Zahra Siddique, Sonia Bhalotra, Uma Kambhampati and Samantha Rawling, looks at whether changes in the labour market and increased employment in India have an impact on crime against women.
 International liquidity and the financial crisis
International liquidity and the financial crisis18 October 2016
William A. Allen worked in the Bank of England from 1972 to 2004, where he was Head of the Money Market Operations Division, Head of the Foreign Exchange Division and Director for Europe.
 Corporate Culture and Enforcement Actions in Banking
Corporate Culture and Enforcement Actions in Banking12 October 2016
Franco Fiordelisi (University of Rome III) discusses enforcement actions as a key tool for supervisors to reduce moral hazard behaviour at all banks, and not just at the banks which have been sanctioned. This event is part of our Weekly Research Seminar Series.
 Japan's astonishing financial survival
Japan's astonishing financial survival10 October 2016
Peter Boone is the Executive Chair of Effective Intervention and a member of the Globalization Program at the Centre for Economic Performance in the London School of Economics.
 The host with the most? The effects of the Olympic Games on happiness
The host with the most? The effects of the Olympic Games on happiness5 October 2016
'The Host with the Most? The Effects of the Olympic Games on Happiness', a new paper by the Centre for Globalisation Research (CGR), aims to answer the question of whether hosting the Olympic games can increase happiness in the host city.
15 June 2016
25 May 2016
13 January 2016
16 December 2015
25 November 2015
18 November 2015
4 November 2015
28 October 2015
21 October 2015
4 February 2015
10 December 2014
1 December 2014
Centre for Government and Leadership - Open Lecture
26 November 2014
19 November 2014
12 November 2014
29 October 2014
22 October 2014
26 March 2014
12 March 2014
11 February 2014
7 October 2013
Varieties of the Worker-Mother and the Challenges for Policy Professor Marian BairdQMUL Humanities and Social Science Distinguished Visitor 2013Professor of Employment RelationsSydney University
11 September 2013
11 June 2013
Professor Mats Alvesson, Lund University, Sweden and Visiting Fellow in the School of Business and Management
20 March 2013
29 February 2012
12 September 2011
8 July 2011
Organised jointly between:CGR - Centre for Globalisation Research, Queen Mary, University of London andCEGBI - Centre for the Evolution of Global Business and Institutions, University of York
13 April 2011
Time: 13.00 - 14.45, Wednesday 13th April 2011
23 March 2011
9 March 2011
School Research Seminar Series - Decomposing Poverty Change: Deciphering Total Change in Population and Beyond
5 February 2014
Organizational Learning Research Group Keynote Lecture: The ‘practice turn’ and the sociomateriality of learning and knowing
22 January 2014
Book Launch and Panel Discussion: Remembering Inflation by Professor Brigitte Granville
16 October 2013
Can adaption beat hindsight? Evidence from investors’ adapting technical trading rules
22 March 2017
School Research Seminar Series - The Language of Banking: theorizing narrative for interpretive research
13 March 2013
Behavioural Finance Working Group Keynote Lecture: The Psychology of Decisions Under Scarcity
16 December 2013
Black History Month Lecture - Taming Corruption: the way forward for African economic development
23 November 2018
Post-crisis Greece: impact on democracy and governance after 8 years of Economic Adjustment Programmes Lecture on 29 October 2018
29 October 2018
SBM Students Want to Advance your Accounting Career? Attend the ACCA Accelerate Event on 11 October 2018
11 October 2018
Wed 3rd October 2018 Research Seminar Series: 'Distribution Neutral Fiscal Policy-Theory and Application.'
3 October 2018
Global Governance Transformed: Explaining the Nexus between the EU and International Organizations
25 September 2015
Seeking Person-Organisation Culture Fit in the Workplace: Unintended Inequalities for Skilled Immigrants
28 September 2016
International Workshop - 'Contemporary challenges, debates and omissions in equality and diversity thinking'
21 September 2011